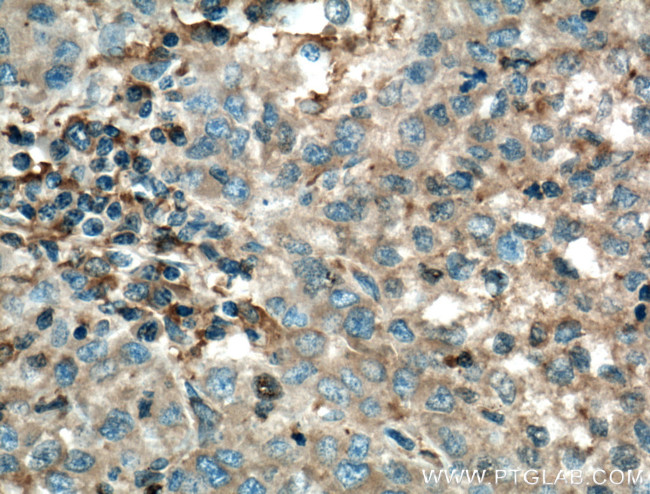
TNFR1 Antibody in Immunohistochemistry (Paraffin) (IHC (P))
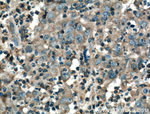
TNFR1 Antibody in Immunohistochemistry (Paraffin) (IHC (P))

Search
Proteintech
TNFR1 Monoclonal Antibody (2A6E3)
{{$productOrderCtrl.translations['antibody.pdp.commerceCard.promotion.promotions']}}
{{$productOrderCtrl.translations['antibody.pdp.commerceCard.promotion.viewpromo']}}
{{$productOrderCtrl.translations['antibody.pdp.commerceCard.promotion.promocode']}}: {{promo.promoCode}} {{promo.promoTitle}} {{promo.promoDescription}}. {{$productOrderCtrl.translations['antibody.pdp.commerceCard.promotion.learnmore']}}
产品信息
60192-1-IG
种属反应
宿主/亚型
分类
类型
克隆号
抗原
偶联物
形式
浓度
规格
纯化类型
保存液
内含物
保存条件
运输条件
产品详细信息
Immunogen sequence: RYQRWKSKL YSIVCGKSTP EKEGELEGTT TKPLAPNPSF SPTPGFTPTL GFSPVPSSTF TSSSTYTPGD CPNFAAPRRE VAPPYQGADP ILATALASDP IPNPLQKWED SAHKPQSLDT DDPATLYAVV ENVPPLRWKE FVRRLGLSDH EIDRLELQNG RCLREAQYSM LATWRRRTPR REATLELLGR VLRDMDLLGC LEDIEEALCG PAALPPAPSL LR (235-455 aa encoded by BC010140)
靶标信息
TNFR1 (Tumor necrosis factor receptor 1) belongs to the tumor necrosis factor superfamily, and is one of the major TNF-alpha receptors. TNFR1 plays an important role in mediating, in cytokine mediated signaling, positive regulation of the NF-Kb pathway, positive regulation of angiogenesis, and negative regulation of gene expression. The extracellular domain of TNFR1 is also released into the circulatory system as soluble TNFR1 (sTNFR1). In humans, the TNFR1 gene is located on chromosome 12. Anti-apoptotic protein BCL2-associated athanogene 4 (BAG4/SODD) and adaptor proteins TRADD and TRAF2 have been shown to interact with TNFR1, and thus play regulatory roles in the signal transduction mediated by the receptor. Germline mutations of the extracellular domains of TNFR1 were found to be associated with the autosomal dominant periodic fever syndrome, and the impaired receptor clearance is thought to be a mechanism of the disease.
仅用于科研。不用于诊断过程。未经明确授权不得转售。
生物信息学
蛋白别名: CD120a; CD120a antigen; MGC19588; n-smase activation assoc. factor; p55; p55 TNF receptor; p60; p62; p63; sCD120a; soluble CD120a; soluble TNFR1; sTNF RI; sTNFR I; sTNFR1; sTNFRI; TNF alpha gene; TNF receptor alpha chain; TNF-alpha-R1; TNF-R1; TNF-RI; TNFR; TNFR I; TNFR-I; TNFR1 beta; tumor necrosis factor binding protein 1; Tumor necrosis factor receptor; Tumor necrosis factor receptor 1; Tumor necrosis factor receptor superfamily member 1A; tumor necrosis factor receptor type 1; Tumor necrosis factor receptor type I; tumor necrosis factor-alpha receptor; unnamed protein product
基因别名: CD120a; FPF; p55; p55-R; p60; TBP1; TNF-alphaR1; TNF-R; TNF-R-I; TNF-R1; TNF-R55; TNFalpha-R1; TNFAR; TNFR-1; Tnfr-2; TNFR1; TNFR55; TNFR60; TNFRI; TNFRp55; TNFRSF1A
UniProt ID: (Pig) P50555, (Human) P19438, (Rat) P22934, (Mouse) P25118
Entrez Gene ID: (Pig) 397020, (Human) 7132, (Rat) 25625, (Mouse) 21937